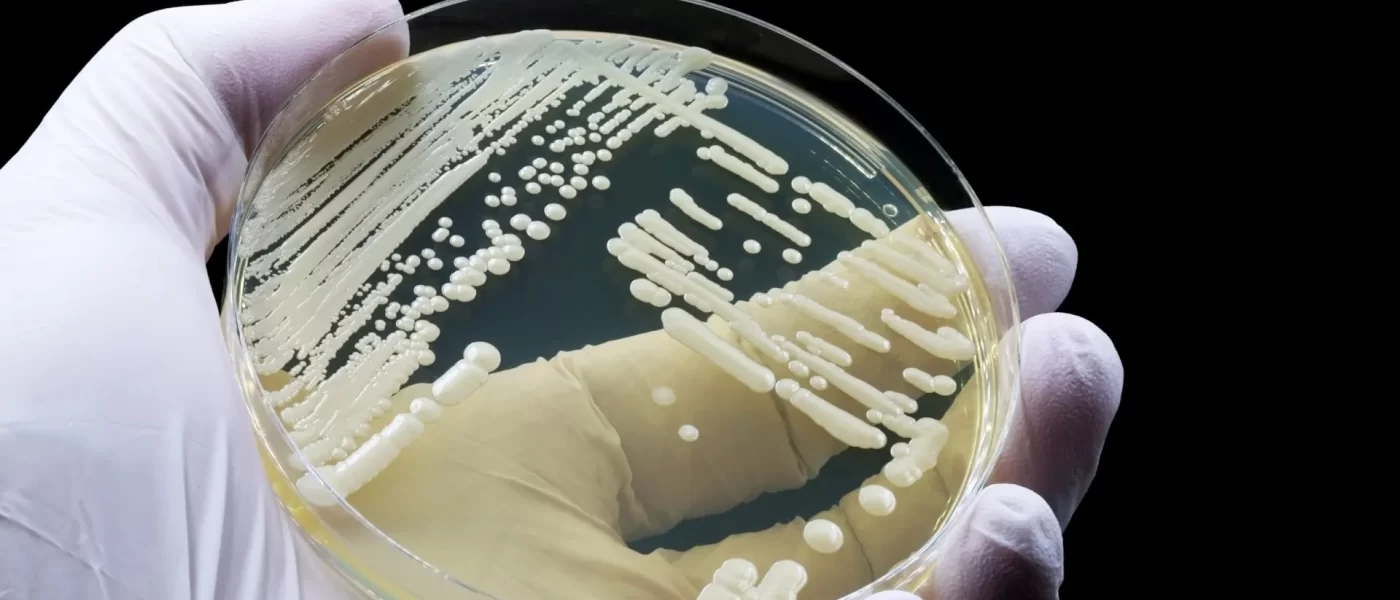

Fungo resistente e perigoso já chegou a Portugal e acende alerta na saúde
[[{“value”:”
Um fungo resistente, de difícil diagnóstico e com potencial letal passou a preocupar autoridades de saúde em toda a Europa após o verão de 2025. Tr…
leia mais no Notícias ao Minuto Brasil aqui.
“}]]